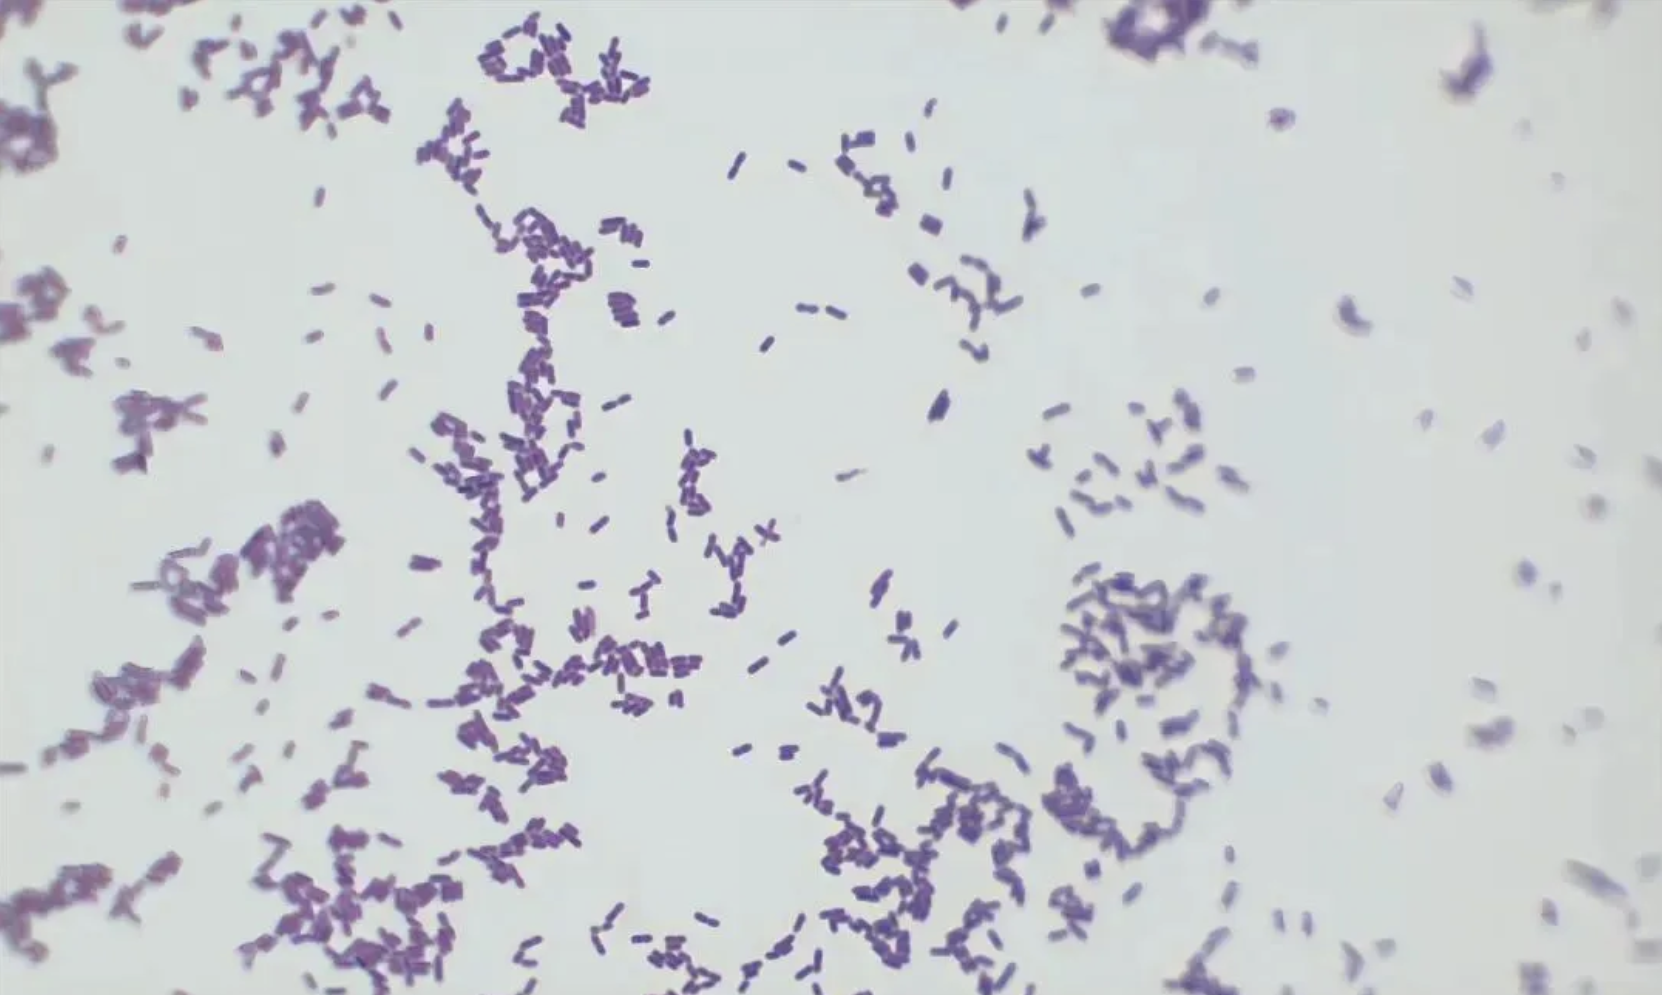

追热点丨孕妇因吃剩菜不幸去世,这个隐匿的“冰箱杀手”别忽视!
大众新闻·半岛新闻 武传英 2026-04-22 20:36:36
近日,#孕妇吃冰箱剩菜后去世# 的话题多次登上媒体热搜,引发广泛关注。据悉,这名孕妇是在吃了冰箱剩菜后感染李斯特菌,经全力抢救,坚持了3个月最终仍不幸离世。

这起事件让人们再次关注到冰箱里的隐匿“杀手”——李斯特菌
李斯特菌有何特点?
感染后有哪些症状?
哪些食物中可能存在李斯特菌?
日常生活中该如何避免感染?
一起来了解↓
什么是李斯特菌?
李斯特菌经常被叫作“冰箱杀手”,许多感染事件的发生都因人们吃了被李斯特菌污染的冷藏即食食品,例如奶制品、熟食肉类、沙拉、三明治和水果等。

冰箱的冷藏温度通常在0°C到4°C之间,可以阻止大部分食源性致病细菌的生长。但李斯特菌能在低至-1.5°C的环境中生存和生长,随着时间的推移,少量的李斯特菌在冰箱冷藏室就能生长繁殖到足以造成危险的污染水平。
显微镜下的李斯特菌。
感染李斯特菌会出现哪些症状?
李斯特菌感染较为隐蔽,大多数健康的成年人被感染后没有症状,或者可能出现轻微的流感症状(如发热、恶心、关节疼痛等),多无特异性。
但是,对于孕妇、新生儿、65岁以上老年人和免疫系统较弱的人而言,李斯特菌感染可能非常凶险:
当人体的免疫系统较弱时,李斯特菌一旦扩散到肠道以外的组织和器官,就可能出现头痛、发烧、肌肉酸痛、颈部僵硬、意识模糊、失去平衡和抽搐等症状。
女性怀孕期间的免疫系统会发生变化,孕妇因此更容易感染李斯特菌。虽然孕妇感染后本人可能只有轻微症状,但细菌会进入胎盘并感染未出生的胎儿,从而引起早产或流产,甚至使新生儿患上重病或死亡。
哪些食物中可能存在李斯特菌?
国家食品安全风险评估中心副研究员韩海红介绍,李斯特菌广泛存在于自然界中,土壤、水、植物都可能是它的藏身之所,食品在生产过程中存在很多被污染的机会。
真空包装的食物
作为一种兼性厌氧细菌,李斯特菌在无氧环境中也能存活,因此,可见于真空包装的熟香肠、火腿、熏肉等食物中。
近地面生长的果蔬
土壤中的李斯特菌在大雨天很容易溅出,溅到生长在地面较低位置的果蔬(例如哈密瓜)的表面或表皮上。哈密瓜的瓜皮上面还有很多网状纹路,不容易清洗干净,当人们切瓜时,李斯特菌就会被带到果肉上。
此外,未经消毒的生鲜奶、沙拉,未清洗的生蔬菜,熟食肉类,部分凉拌菜、预切水果和机打冰淇淋都可能产生李斯特菌。


不怕冷但怕热
5招防范李斯特菌
虽然李斯特菌能在冰箱里的低温环境下繁殖,但它有个“软肋”:不耐热。牢记以下这5点,不让它找上门!
清理冰箱
定期清理冰箱,避免各种细菌繁殖。
生熟分开
生的畜肉、禽肉和海产品应与其他食物分开处理和存放;处理生食要使用专门的砧板刀具,每次使用后要洗净、晾干。
煮熟烧透
李斯特菌“怕热”,在70°C下加热5分钟即可消灭。生食要彻底煮熟,尤其是肉、禽、蛋和海产品;熟食类的肉制品从冰箱取出后,也应高温加热后再食用。
保持清洁
做饭时应确保手、原料、操作台和厨具的清洁;吃东西前后要洗手。
远离高风险食品
免疫力较差人群和孕妇应尽量避免食用机打冰淇淋、凉拌菜、三明治、生乳酪、沙拉等生食。
大众新闻·半岛新闻综合自国家应急广播、央视新闻客户端、健康中国、广东疾控等
责任编辑:武传英
